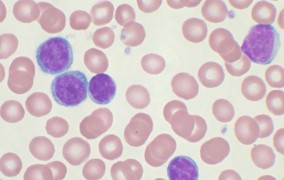

Oportunidades - Bolsas FAPESP
-
Pós-doutorado em redes inteligentes de energia na Unesp
28 de outubro de 2020As principais atividades do bolsista estarão relacionadas ao desenvolvimento de técnicas de gerenciamento energético, integrando fontes renováveis e armazenadores -
Doutorado direto em genética e biologia molecular de dermatófitos na USP
27 de outubro de 2020Vaga é para projeto conduzido na Faculdade de Medicina de Ribeirão Preto. Objetivo é investigar mecanismos moleculares associados à patogenicidade e resistência em fungos que causam doença de pele -
Vaga de pós-doutorado no Instituto de Tecnologia de Alimentos
27 de outubro de 2020Bolsista desenvolverá pesquisa sobre metabólitos produzidos por fungos e suas aplicações em taxonomia e biotecnologia. Inscrições até 6 de novembro -
Treinamento técnico em microbiologia na Faculdade de Ciências Médicas da Unicamp
26 de outubro de 2020Bolsista integrará equipe de laboratório que utiliza técnicas microbiológicas, imunológicas e moleculares para o desenvolvimento de seus projetos -
Pós-doutorado em ecotoxicologia na UFSCar e na Unifesp da Baixada Santista
26 de outubro de 2020Bolsista atuará em estudo experimental em laboratório e campo com invertebrados e em análises físicas de nanopartículas -
Doutorado direto em Física Matemática na USP de São Carlos
23 de outubro de 2020Podem concorrer à bolsa alunos do último semestre de graduação ou graduados sem mestrado concluído nas áreas de matemática, física ou afins -
Pós-doutorado em Teoria de Singularidades e visão computacional na USP de São Carlos
23 de outubro de 2020Projeto tem o objetivo de estreitar a lacuna entre a visão computacional e geometria, permitindo explicar o aprendizado de características visuais em diferentes domínios ou representações -
Doutorado direto em ressonância magnética nuclear na Unicamp
22 de outubro de 2020Pesquisa avalia as condições de extração e o perfil metabólico de soja cultivada na presença e ausência de nanopartículas de prata, cobre e sílica -
Pós-doutorado em imunometabolismo na Unicamp
22 de outubro de 2020Candidatos devem ter experiência em biologia molecular, biologia celular e imunologia. Prazo de inscrição termina em 1º de novembro -
Pós-doutorado em redes de computadores no Instituto de Computação da Unicamp
21 de outubro de 2020Projeto investiga novas arquiteturas, mecanismos e ferramentas para dotar a infraestrutura de capacidade para lidar com as demandas desafiadoras impostas pelo processamento de big data -
Treinamento técnico em química analítica no Instituto de Geociências da USP
21 de outubro de 2020Os bolsistas serão treinados em uma rotina de laboratório de pesquisa voltado à análise isotópica com uso de espectrômetro de massa de fonte gasosa do tipo IRMS -
Pós-doutorado em linguística computacional no IME-USP
20 de outubro de 2020Bolsista participará de atividades de pesquisa na área de interface entre inteligência artificial, processamento de sinais e medicina -
Treinamento técnico em psicologia na Unifesp de Guarulhos
20 de outubro de 2020São oferecidas duas vagas em projeto que investiga impactos de adversidades maternas no neurodesenvolvimento. Bolsistas vão atuar na triagem de pacientes, aplicação de escalas e manutenção de contato com o sujeito de pesquisa, entre outras atividades -
Pós-doutorado em aprendizado de máquina e visão computacional no IME-USP
19 de outubro de 2020Projeto de que bolsista irá participar busca o desenvolvimento de métodos computacionais para acelerar a anotação e classificação de imagens de plânctons. Estudo faz parte do acordo entre a FAPESP e o Belmont Forum -
Treinamento técnico em cultivo celular e engenharia de tecidos
16 de outubro de 2020Candidato deve ser graduado em farmácia, ciências biológicas ou áreas afins para trabalhar com reconstrução de tecidos bioimpressos em laboratório de biofabricação -
Pós-doutorado em ornitologia no Museu de Zoologia da USP
15 de outubro de 2020Candidato deve ter experiência em trabalho de campo, laboratório e em análises computacionais, além de disponibilidade para trabalhar parte do tempo no Estado de Alagoas, no estudo de endemismos de aves na região -
Pós-doutorado em sistemas de comunicação sem fio na PUC-Rio
14 de outubro de 2020Dois bolsistas serão financiados por meio de um acordo entre a FAPESP e os ministérios da Ciência, Tecnologia e Inovações e das Comunicações para estudos da internet no Brasil -
Pós-doutorado em gestão de risco de desastres na Faculdade de Saúde Pública da USP
13 de outubro de 2020Bolsista terá atividades em projeto sobre modelos de inundação e na criação de indicadores de vulnerabilidade. O pós-doutorando trabalhará em colaboração com o Instituto Indiano de Tecnologia, da Índia -
Treinamento técnico em administração pública na FGV-SP
13 de outubro de 2020Projeto visa avaliar medidas de enfrentamento à pandemia de COVID-19. Bolsista realizará pesquisa de campo e análise dos dados e dará apoio a eventos de divulgação científica -
Centro de Pesquisa em Engenharia abre oito vagas de treinamento técnico
09 de outubro de 2020Bolsistas vão integrar a equipe do Centro de Pesquisa em Engenharia Fitossanidade em Cana-de-Açúcar, que desenvolve estudos básicos e aplicados sobre o manejo de pragas em Jaboticabal e em Ribeirão Preto -
Pós-doutorado em curadoria de coleções no Instituto Biológico
09 de outubro de 2020As atividades do bolsista incluem análises morfológicas e moleculares de Hymenoptera parasitoides, incluindo montagem de espécimes -
Doutorado direto em imunometabolismo
08 de outubro de 2020Bolsista vai investigar o papel da dinâmica mitocondrial na ativação de macrófagos, com o objetivo de compreender o processo de envelhecimento. Projeto é realizado na Unicamp e na USP e tem parceria com a NWO, dos Países Baixos -
Pós-doutorado em internet das coisas e computação em nuvem
08 de outubro de 2020Bolsista deverá buscar soluções para arquitetura de dados mais adequada para atender aos requisitos das aplicações de IoT assistida por cloud computing -
Treinamento técnico em tecnologia da informação
07 de outubro de 2020Empresa com apoio do PIPE-FAPESP oferece duas vagas, uma para desenvolver sensor para detecção de moscas-das-frutas e outra para criar armadilha de monitoramento automatizado do besouro bicudo-do-algodoeiro -
Vaga de jornalismo científico em governança ambiental no Instituto de Energia e Ambiente da USP
06 de outubro de 2020Projeto mobiliza dezenas de pesquisadores em vários campos de atuação com o objetivo de identificar problemas ambientais da macrometrópole paulista -
Pós-doutorado em epidemiologia nutricional na Faculdade de Medicina da USP
06 de outubro de 2020Objetivo do projeto é analisar na população de Portugal a associação do padrão de consumo de alimentos ultraprocessados com um amplo conjunto de indicadores da qualidade da dieta -
Pós-doutorado em química de produtos naturais no CNPEM
05 de outubro de 2020Bolsista participará de pesquisa relacionada à purificação de produtos de metabolismo secundário de bactérias e plantas. Candidatos devem possuir título de doutor recente em química ou área correlata -
Doutorado direto na USP em conservação de aves na Caatinga
02 de outubro de 2020São oferecidas três vagas em projeto sobre ecologia e conservação da arara-azul-de-lear e urubus. Inscrições abertas até 20 de outubro -
Mestrado e doutorado direto em mecânica dos fluidos computacional na USP
02 de outubro de 2020Podem concorrer alunos do último semestre de graduação ou graduados sem mestrado concluído nas áreas de ciência da computação, matemática, engenharia ou áreas afins -
Pós-doutorado em psiquiatria na Faculdade de Medicina da USP
01 de outubro de 2020Bolsista vai participar de estudos sobre a integração de fatores de risco genéticos e ambientais para identificar marcadores biológicos relacionados a transtornos do neurodesenvolvimento -
Treinamento técnico em comunicação e computação na Unifesp
01 de outubro de 2020Duas vagas estão disponíveis em projeto que faz a análise de dados, operação do site e produção de releases para a Agência de Inovação Tecnológica e Social da universidade. Inscrições até 16 de outubro -
Treinamento técnico em programação e internet das coisas em startup com apoio do PIPE
30 de setembro de 2020Duas vagas são oferecidas na empresa Caronetas Caronas Inteligentes. Bolsistas vão trabalhar com desenvolvimento, homologação, precisão e segurança das informações -
Pós-doutorado em equações diferenciais parciais na UFSCar
30 de setembro de 2020Pesquisa será centrada no estudo dos complexos diferenciais associados a estruturas localmente integráveis. Inscrições até 15 de outubro -
Treinamento técnico em engenharia da computação
29 de setembro de 2020Oportunidade é oferecida em empresa de tecnologia agrícola de Ribeirão Preto que recebe apoio da FAPESP por meio do Programa Pesquisa Inovativa em Pequenas Empresas -
Pós-doutorado em espectroscopia Raman na Unesp
29 de setembro de 2020Projeto de pesquisa terá atividades experimentais em técnicas como síntese de coloides de nanopartículas metálicas em sensores para detecção de pesticidas -
Pós-doutorados em biofotônica no Instituto de Física de São Carlos da USP
28 de setembro de 2020Centro de Pesquisa em Óptica e Fotônica apoiado pela FAPESP dispõe de quatro vagas em projetos que buscam soluções inovadoras em tecnologias que utilizam a luz como fonte terapêutica -
Pós-doutorado em descoberta de fármacos na USP
28 de setembro de 2020Bolsista vai realizar experimentos bioquímicos e celulares para a análise de compostos com potencial bioativo no Instituto de Ciências Biomédicas -
Treinamento técnico em manufatura aditiva e programação
25 de setembro de 2020Empresa apoiada pelo PIPE-FAPESP oferece vaga em projeto na área de engenharia de tecidos biológicos. Inscrições até 10 de outubro -
Mestrado em biologia molecular de parasitos na Unesp de Botucatu
25 de setembro de 2020Dois bolsistas terão a oportunidade de aprender e aplicar técnicas moleculares clássicas e atuais, além de interagir com diferentes grupos, nacionais e estrangeiros -
Doutorado direto em biotecnologia e engenharia metabólica na Unicamp
24 de setembro de 2020Projeto Temático abre três vagas para participação em pesquisa que desenvolve a implementação de tecnologia de segunda geração (2G) para a produção sustentável de bioetanol da cana-de-açúcar -
Pós-doutorado em sistemas e equações diferenciais parciais na Unicamp
23 de setembro de 2020Estão disponíveis três vagas em projeto que estuda os aspectos matemáticos que possuem grande interação com problemas geométricos, modelos de reação e difusão, entre outros -
Treinamento técnico em nanotecnologia em startup apoiada pelo PIPE
22 de setembro de 2020Bolsista deverá auxiliar pesquisadores do projeto no desenvolvimento do kit liofilizado de nanopartícula de albumina para aplicações radiofarmacêuticas -
Centro de Pesquisa em Engenharia tem vaga de pós-doutorado em gerenciamento de produção
21 de setembro de 2020Pesquisador participará de pesquisa que busca a otimização da extração de petróleo e gás utilizando modelos numéricos de simulação de reservatórios -
Bolsa de mestrado em metabolismo na Unicamp
21 de setembro de 2020No Centro de Química Medicinal, bolsista participará de projeto que estuda a expressão da proteína BICC em células tumorais para identificar mRNAs alvos -
Treinamento técnico em biofabricação em empresa com apoio PIPE-FAPESP
21 de setembro de 2020Bolsista trabalhará no desenvolvimento de enxertos vasculares e tecidos vascularizados. Vaga exige experiência interdisciplinar em engenharia de tecidos -
Pós-doutorado em física atmosférica na USP
18 de setembro de 2020Bolsista vai realizar simulações de grandes redemoinhos (LES) de nuvens para identificar possíveis modificações causadas pelo aumento da poluição por aerossóis -
Treinamento técnico em psicologia na Unifesp
17 de setembro de 2020Bolsa se destina a psicólogo, de preferência com especialização em curso ou concluída em neuropsicologia e interesse ou experiência em atividades de pesquisa -
Pós-doutorado em sistemas de computação na Unesp de Rio Claro
17 de setembro de 2020Bolsista trabalhará com pesquisa e desenvolvimento de técnicas de otimização para escritas rápidas e consistentes em memórias -
Pós-doutorado em otimização topológica no Centro de Ciências Matemáticas Aplicadas à Indústria
16 de setembro de 2020Bolsista participará de projeto de otimização da topologia de propriedades mecânicas estruturais aplicadas à fusão por feixe de elétrons -
Doutorado direto em soluções baseadas na natureza no Instituto de Botânica
16 de setembro de 2020Bolsista desenvolverá estudos em três parques da cidade de São Paulo para determinar a quantidade de carbono assimilado e o volume de água transpirado em várias espécies de árvores
Mais lidas do mês
-
Fungo patogênico transmitido pelo arranhão do gato doméstico está presente em animais selvagens
19 de junho de 2026
-
Cientistas propõem medidas para conter avanço de fungos resistentes a medicamentos
23 de junho de 2026
-
Homens idosos que dormem mais de nove horas têm maior risco de perder mobilidade
22 de junho de 2026
-
Corpo aproveita pouco os minerais das castanhas, diz estudo que simulou a digestão humana
11 de junho de 2026
-
São Paulo terá a primeira usina do país para capturar e armazenar carbono do etanol de cana
11 de junho de 2026
-
Relógio inteligente detecta ansiedade e estresse em tempo real
08 de junho de 2026
-
O cientista brasileiro que liderou a digitalização de 400 anos de história da flora do planeta
16 de junho de 2026
-
Pesquisadoras descobrem nova espécie de microrganismo adaptado a frio e calor extremos na Antártida
01 de junho de 2026
-
Estudo detalha como o organismo se adapta a dietas com muita proteína e nenhum carboidrato
15 de junho de 2026
-
Nova técnica identifica estrelas que engoliram planetas
16 de junho de 2026